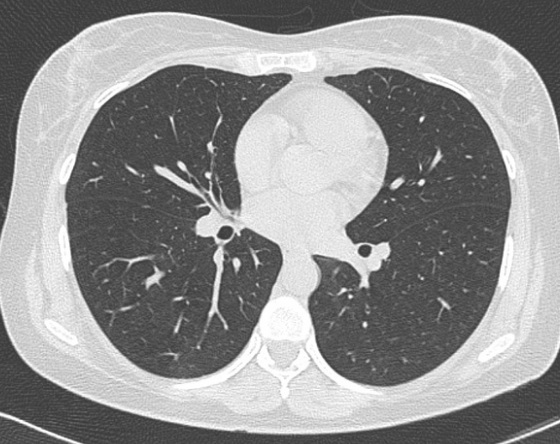

|
Les techniques radiologiques du thorax comprise : la
rx sans préparation, la tomodensitométrie (TDM), l'imagerie
par résonance magnétique (IRM), la scintigraphie, la PET
(positron emission tomography) et l'échographie
La radioscopie
: C'est la technique radiologique
se presenter depuis longtemp , permettrait etudier la dimension ,la relation anatomique des organes , des lesions intrathoraciques ou de la
paroi thoracique , a etat
dynamique . Avec des exposants de face , de profile ,
OAD , OAG aux degree correspondance nous pouvons detecter
aussi la cite des lesions et sa relation que les plains films
du technique radiographie ne peut etre
realiser . La faiblesse de cette methode c'est la moins
de detecte des petit lesions Mais des que la
developpement de l'amplificateur de brillante du rayon X
, la radioscopie avait quelque changement favorisee ..
| |
|
|
|
|
| |
 |
|
 |
|
| |
Avec la machine
radioscopique ancienne la dose de radioactif ( rem )
sur maladie et de la medecine sont marques. Et
tout les examinations sont encore en ombre .
|
|
Par la developpement de l'amplificateur de brillante
de rayon X ( place en avant ou arriere du maladie , a cote oppose
du tube de rayon X ) , la radioscopie avait quelque changement
favorable .La dose rem du maladie et de la medecine diminuent plusieure
de fois de plus ; a la cite place en outre de la
chambre d'examination et a tableau de bord , la dose est presque
inconsiderable .
L'examination sur la maladie en ce moment , c'
est en totalement sous la lumiere de lampe de
fluorescence normale de la chambre .Et par ceux
chics quelque inventions dans la technique
chirurgical avaient developpe . |
|
La radiographie : Selon la situation de la
lesion , les graphies du thorax se base sur :
le
plain film de face ( AP ou PA ) , Les cliches de
profile droit ou gauche , a position OAD et OAG avec
angle
corresponsdance . Pour etudier la relation anato -
pathologique des lesion et de organe avec oesophage on
peut represente des cliches avec une repas
baryte . La
orthodiagraphie
: methode simple et sedusant pour tenir si precisement
la
dimension de l'ombre du coeur et l'indice coeur /
pulmonaire du maladie. La resulta c'est la ecriture du trajet du bord du
coeur qui s'imprime sur le papier . La
teleradiographie du
thorax
a
haute tension
, technique simple pour
remplace la orthodiagraphie et peut diminue effet de la
radioactif.de maladie . Le foyer du tube rayon X se place une
distance de 1,6 -1,8 m au malade et le film , ce
qui diminue l'effet de agrandir du images .La
kymographie , technique
radiologique ancienne
pour
etudie l'amplitude du coeur et du diaphragme .
La bronchographie a
lipiodol fluid , ultra fluid ou avec de contrast
hydrosouble . Technique radiologique etudie directement en image les
lesions tracheale ou brochiolaires segmentaires
. La
Tomographie lineaire
( planningraphy ) Une
technique radiologique simple pour atteint une
coupe a travers la cite marquee de la lesion . Par une " Cassette de livre " on peu avait plusieure de
cliche a difference de couche a travers la lesion en par un
seulement de expose ( Tomographie simultanee ).Technique digitalisation et traitant de
images radiologiques thoracique analoque :
LUMT**
((Linear Unsharp Masking Technique) et
LCS
(Local Contrast Stretching )
La
Xerographie du thorax
**:
Technique radiologique a film exposant seche ,
la cassette ancienne est remplace par une detecteur plan
de selenium :
cassette numerique
**,la resulta est une image en digitalisation
... .Tomographie
axiale : Technique
ancienne pour avait en images une coupe horizontal du
thorax . Mais tous sont en sombre dans le diagnostic et
explorer du thorax des que a la presence de
technique ( TDM ) du thorax , ce que fournit de image du thorax
plus precises en coupe axiale et coronale .
Angiographie
pulmonaire :
technique radiologique a expose des films en serie avec
de contrast hydrosoluble intra-arterienne pour etudie de
abnormalie lesionaire de artere pulmonaire ou de artere
bronchique
| |
 |
|
 |
|
| |
Schema de
radiographie pulmonaire en position debout PA (
postero -anterieure ) . Distance francissable etre
1,2m - 1,4m , rayon central est à horizontale
et situe à T7 . Cliche expose en prise au temps
apnee au cours de phase inspiration |
|
Les quatres posisions radiographiques de
base du thorax en position AP , PA (
postero-anterieur) , apico lordotique et profile
gauche . La distance trancissable etre 1,2 -
1,4m et le foyer central du rayon en place à T7 ou
au milieu de la ligne de deux bord inferieure de
l'omoplate |
|
| |
 |
|
 |
|
| |
Standard cliche de
radiographie de face ( PA ) et de profile gauche du
poumon .en position debout |
|
Avec les deux cliches OAG et OAD a angle
precedent , on peut detecter la lesion marquee en outre de
l'ombre du coeur et de la colonne vertebrale . Et par la meme
technique ,
quelques courbures de la silhouette du coeur avaient aussi detecte ... |
|
| |
 |
|
|
|
| |
La
Tomographie lineaire
( planningraphie ) Une
technique radiologique simple pour atteint une
coupe a travers la cite marquee de la lesion . Le
plan du coupe ( objet 1 ou objet 2 ) verifie par
intersection géométrique des diagonales des rayons
centrals |
|
Photo
reele d'une radiograph planigraphie Avec une "
Cassette de livre " on peu avait plusieure de
cliche a difference de couche a travers la lesion en
par un seulement de expose ( Tomographie simultanee
) |
|
| |
 |
|
 |
|
| |
La bronchographie : Par le sonde de Metras , 8 - 10 cc de contrast
lipiodol avait injecte selective dans la bronche souche droit ou
gauche .Image de cela et
ses branches sont bien detecte sur le film .en position OAG
|
|
Image bronchographie de arbre bronchique droit
en cliche de face
|
|
| |
|
|
|
|
La TDM du
thorax :
Tomodensitographie computerisation
(TDM)
du thorax fournit des images plus précises qu'une simple
radiographie. Avec la tomodensitométrie ( CT ), une série de
rayons X est analysée par un ordinateur, qui fournit ensuite
plusieurs vues depuis différents plans, telles que des vues
longitudinales et des coupes transversales. Pour explorer le
thorax Il y avait deux fenetre explorer : fenetre
parenchymateuse pulmonaire et
fenetre mediastinale ou oseuse .
Lors du scanner, une substance visible sur les radiographies
(produit de contraste radio-opaque) peut être injectée dans
la circulation ou par voie orale peut en préciser la nature
de certaines anomalies thoraciques. La tomodensitométrie
haute résolution et la tomodensitométrie spirale sont des
procédures tomodensitométriques plus spécialisées. La
tomodensitométrie haute résolution peut révéler plus de
détails sur les maladies pulmonaires. Coronal CT peut
fournir des images tridimensionnelles et on peut en
receillir image du thorax en troi plan axiale , frontal (
coronal ) ou sagitale . En généralement , les
tomodensitogrammes sont effectués explorer après en prise
une profonde inspiration , les images tomodensitométriques
sont obtenues après que les personnes inspirent et expirent
pour mieux visualiser les petites voies respiratoires. du
poumon . La technique de TDM de ultrabase de dose
efficace UBD peut
diminution de dose expose minimum ( egalite la dose d'une
cliche expose pulmonaire de face et de profile en egale =
0,13mSv ) et augemente la detail d'analyse des lesions
pulmonaires . L'angio-TDM utilise un bolus de produit
de contraste IV pour mettre en évidence les artères
pulmonaires, ce qui est utile dans le diagnostic de
l'embolie pulmonaire. La charge de produit de contraste est
comparable à celle de l'angiographie conventionnelle, mais
l'examen est plus rapide et moins invasif. Plusieurs études
ont confirmé la fiabilité de l'angiographie scanner dans la
détection des embolies pulmonaires ..Et enfin la
technique
TDM spectrale
(
Scanner
spectral
) c'est la technique TDM qui consiste à utiliser différentes
énergies du rayon X pour obtenir des images caractéristiques
des tissus et ce qu'il peut d'explorer
l’implication sur le système
vasculaire pulmonaire
par la perfusion et d'analyse
des modifications de la perfusion du systeme vasculaire
pulmonaire à
différents stades de l’affection
| |
 |
|
|
|
| |
Image
radiologique TDM normale en coupe axiale , fenetre
mediastinale ( osseuse ) . Le parenchyme du poumon
en vue de moins nette et en moindre de detail de parenchyme pulmonaire |
|
Même cas en fenêtre parenchymateuse La
parenchyme du poumon , artere, veine pulmonaire et
les deux bronche hilaire etre en vue tres nette .
Image radiologique TDM en coupe axiale , fenêtre
parenchymateuse |
|
| |
 |
|
 |
|
| |
Même cas en fenêtre
parenchymateuse , coupe frontal La parenchyme
du poumon , artere, veine pulmonaire , trache et les
deux bronche hilaire etre en vue tres nette . Image
radiologique TDM en coupe coronal , fenêtre
parenchymateuse |
|
Image radiologique TDM normale du poumon
en coupe sagital , fenetre parenchymateuse |
|
| |
 |
|
 |
|
| |
Image radiologique TDM
pulmonaire en coupe
axial avec de contrast intraveineuse . Aort
thoracique , artere , veine pulmonaire peut en vue
tres nette . |
|
Même cas en coupe axiale , fenetre
parenchymateuse |
|
| |
 |
|
La TDM spectrale , c'est la technique qui consiste à
utiliser différentes énergies du rayon X pour
obtenir des images caractéristiques des tissus
et ce qu'il peut d'explorer
l’implication sur le système
vasculaire pulmonaire
par la perfusion et d'analyse
des modifications de la perfusion du systeme vasculaire
pulmonaire à
différents stades de l’affection
|
|
| |
|
|
|
|
| |
|
|
|
|
A
suivre >
Dr Bui Binh Tho
NEXT >>
|
|